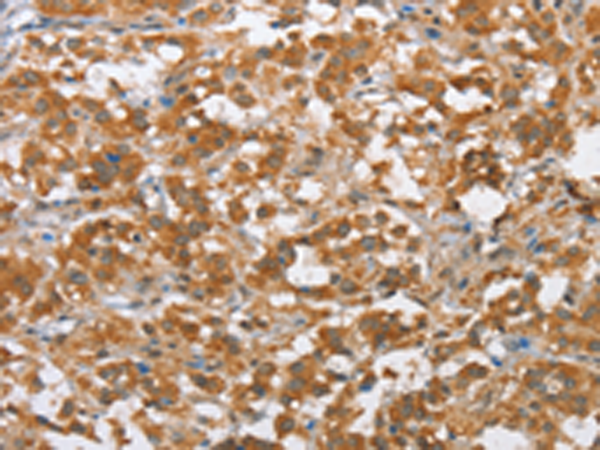
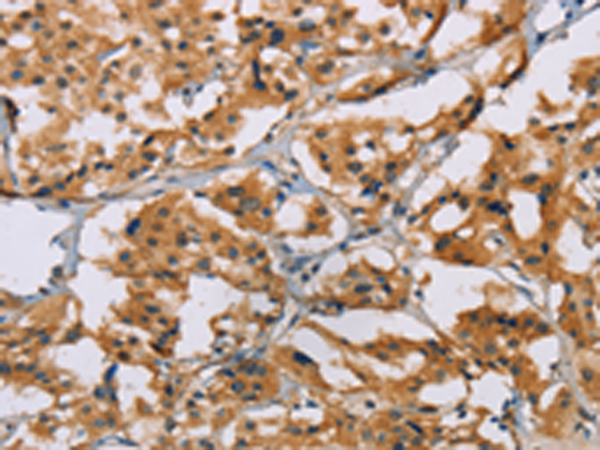
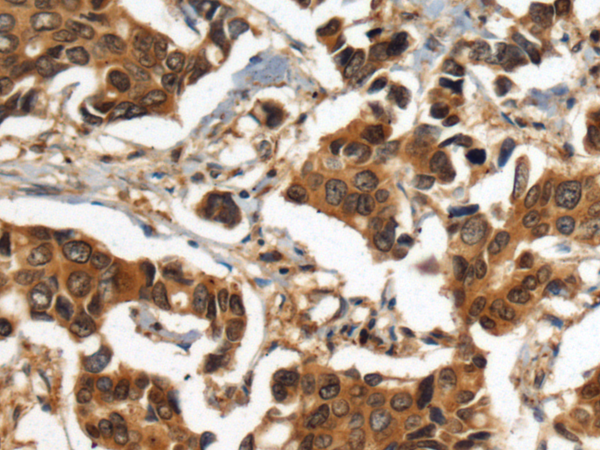
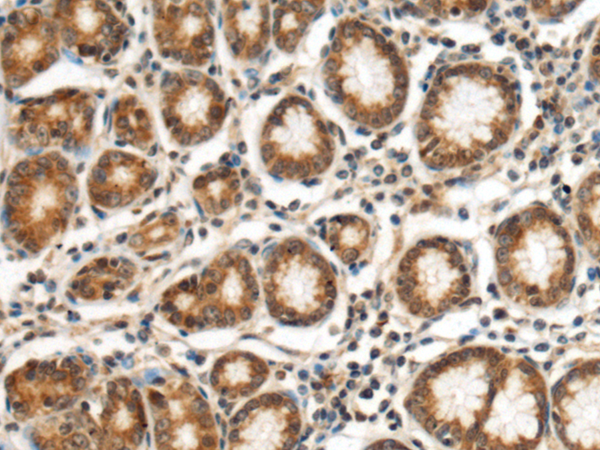

-
分类: 科研抗体货号: P07449别名: SA; LBP; LRP; p40; 67LR; lamR; 37LRP; LAMBR; LAMR1; LRP/LR; LBP/p40; NEM/1CHD4应用: WB,IHC反应种属: Human, Mouse, Rat
-
分类: 科研抗体货号: P07462别名: FCC2; COCA2; HNPCC; hMLH1; HNPCC2应用: IHC反应种属: Human, Mouse, Rat
-
分类: 科研抗体货号: P07469别名: MYH应用: WB,IHC反应种属: Human
-
分类: 科研抗体货号: P07448别名:应用: WB,IHC反应种属: Human
-
分类: 科研抗体货号: P07460别名: GTBP; HSAP; p160; GTMBP; HNPCC5应用: WB,IHC反应种属: Human, Mouse
-
分类: 科研抗体货号: P07468别名: MLC2; CMH10应用: WB反应种属: Human, Mouse, Rat
-
分类: 科研抗体货号: P07477别名: NRN; dJ380B8.2应用: IHC反应种属: Human, Mouse, Rat
-
分类: 科研抗体货号: P07457别名: HEL70应用: WB,IHC反应种属: Human, Mouse, Rat
-
分类: 科研抗体货号: P07467别名: CS-2; FATZ; MYOZ应用: WB,IHC反应种属: Human, Mouse
-
分类: 科研抗体货号: P07476别名: NCK, nck-1, NCKalpha应用: WB,IHC反应种属: Human, Mouse

鄂公网安备42018502007531号
鄂公网安备42018502007531号

